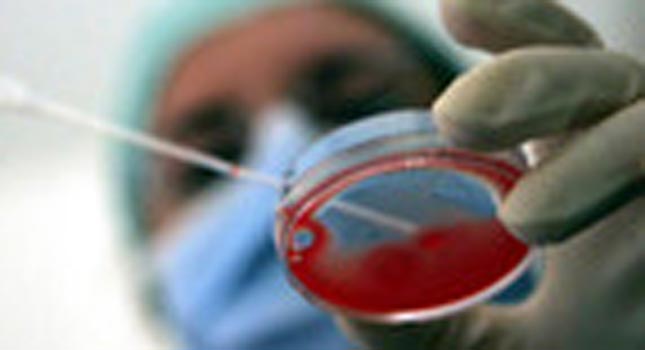

Il 4 dicembre dello scorso anno presso l’ospedale Pertini di Roma è, presumibilmente, stato commesso un errore nelle procedure di procreazione assistita, che ha generato uno scambio di embrioni. Un errore procedurale che avrebbe conseguenze enormi per tutte le persone coinvolte, gli operatori, i genitori e i nascituri.
In termine tecnico si chiama “evento avverso grave”. Purtroppo, sono riportati in letteratura alcuni rari altri casi simili. Mai però in Italia fino ad oggi in 30 anni di attività e migliaia di casi effettuati. L’errore umano è sempre stato all’origine di queste tragedie. Per evitare tali errori i centri di Procreazione Assistita applicano procedure validate per l’identificazione delle cellule in ogni fase del trattamento. Oltre alla Legge 40/2004 e alle successive linee guida, l’Italia recepisce nel 2007 con decreto 191 una normativa europea che si occupa tra l’altro di questo aspetto. Tutte normative attualmente in vigore, e che potranno essere applicate anche per l’implementazione delle tecniche di inseminazione eterologa come predisposto dalla Corte Costituzionale in questi giorni.
I centri italiani hanno quindi da anni gli strumenti normativi e delle stringenti linee guida che permettono di effettuare procedure sicure durante la lavorazione delle cellule. Se queste procedure sono messe in atto, il tasso di errore residuo si riduce drasticamente e, pur non potendo essere escluso, risulta del tutto improbabile. I processi di procreazione assistita vengono infatti effettuati sempre in presenza di testimoni (che possono essere altri operatori o sofisticati sistemi automatizzati) che verificano ad ogni passaggio, sia in sala operatoria che in laboratorio, che l’operatore stia effettuando le procedure in modo corretto e che le cellule siano identificate in modo univoco. Ciò che sembra essere successo oggi è quindi evidentemente un episodio isolato.

L’Associazione Luca Coscioni è una associazione no profit di promozione sociale. Tra le sue priorità vi sono l’affermazione delle libertà civili e i diritti umani, in particolare quello alla scienza, l’assistenza personale autogestita, l’abbattimento della barriere architettoniche, le scelte di fine vita, la legalizzazione dell’eutanasia, l’accesso ai cannabinoidi medici e il monitoraggio mondiale di leggi e politiche in materia di scienza e auto-determinazione.